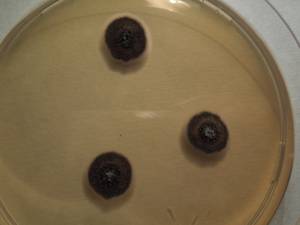
MSU_FS-01535 01, Район Тан Фу (Tân Phú districts), Đồng Nai province (Vietnam)
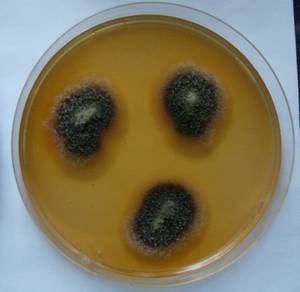
MSU_FS-00251 01, Район Тан Фу (Tân Phú district), Đồng Nai province (Vietnam)

Total items: 6
Total pages: 1
Organisms

- Specimen ID
- 0000002675925
- Species
- Gliomastix murorum
- Strain
- F-547
- Place of isolation
- Данковский район, Lipetsk Oblast (Russia)
- Placename
- Полибино
- Synonyms
- Acremonium murorum

- Specimen ID
- 0000002675929
- Species
- Gliomastix murorum
- Strain
- F-549
- Place of isolation
- Krasnodar Krai (Russia)
- Placename
- Краснодар
- Synonyms
- Acremonium murorum

- Specimen ID
- 0000002675927
- Species
- Gliomastix murorum
- Strain
- F-548
- Place of isolation
- Krasnodar Krai (Russia)
- Placename
- Краснодар
- Synonyms
- Acremonium murorum

- Specimen ID
- 0000002675772
- Species
- Gliomastix murorum
- Strain
- F-479
- Place of isolation
- Данковский район, Lipetsk Oblast (Russia)
- Placename
- Полибино
- Synonyms
- Acremonium murorum
- Specimen ID
- 0000000904402
- Species
- Gliomastix murorum
- Strain
- MSU_FS-01535
- Place of isolation
- Район Тан Фу (Tân Phú districts), Đồng Nai province (Vietnam)
- Placename
- Нам Кат Тьен (Nam Cát Tiên)
- Synonyms
- Acremonium murorum
- Specimen ID
- 0000000903274
- Species
- Gliomastix murorum
- Strain
- MSU_FS-00251
- Place of isolation
- Район Тан Фу (Tân Phú district), Đồng Nai province (Vietnam)
- Placename
- Нам Кат Тьен (Nam Cát Tiên)
- Synonyms
- Acremonium murorum